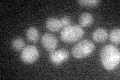
YMR202W
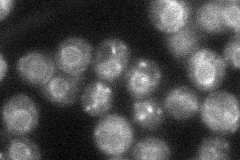
YMR202W
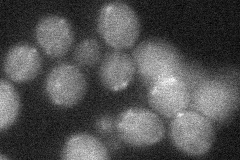
YMR202W
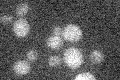
YMR202W

View description
C-8 sterol isomerase, catalyzes the isomerization of the delta-8 double bond to the delta-7 position at an intermediate step in ergosterol biosynthesis
Localization:
Intensity:
Fold change:
Significance:
-
C’ GFP library in SD
below threshold15.69 -
N' NOP1pr-GFP in SD

ER,punctate133.787 -
N' TEF2pr-mCherry in SD

ER,punctate242.207 -
N' NATIVEpr-GFP in SD
ER,punctate35.6577 -
N' TEF2pr-VC and Cyto-VN in SD
below threshold26.6474 -
C’ GFP library in SD+DTT

cytosol15.440.98No -
C’ GFP library in SD+H2O2

cytosol14.10.89No -
C’ GFP library in Starvation Media
cytosol15.650.99No -
C’ GFP library on the background of Pup2-DaMP

below threshold -
C’ GFP library on the background of CCT mutant

below threshold15.53660.989929No
